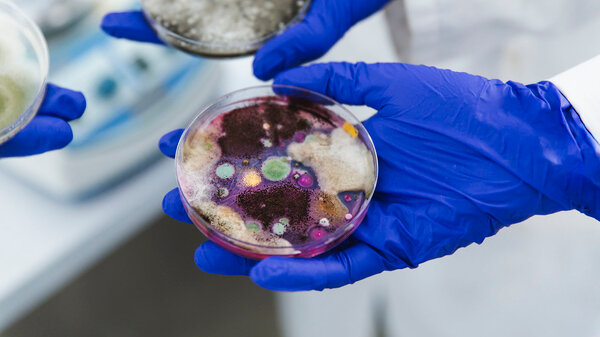

Fosfomycin Aristo Wie Lange Nicht Auf Toilette

Habt ihr euch jemals gefragt, warum manche Medikamente so schnell wirken und andere etwas länger brauchen, bis man eine Veränderung bemerkt? Und habt ihr euch speziell bei Blasenentzündungen mal gefragt, wie lange es eigentlich dauert, bis das Antibiotikum Fosfomycin Aristo anfängt zu wirken und die ständige Rennerei zur Toilette endlich aufhört? Das ist nicht nur eine super praktische Frage, sondern bietet auch einen spannenden Einblick in die Wirkungsweise von Medikamenten und die Reaktion unseres Körpers darauf. Los geht's mit einer kleinen Entdeckungsreise in die Welt der Harnwegsinfekte und ihrer Behandlung!
Fosfomycin Aristo ist ein Antibiotikum, das häufig bei unkomplizierten Harnwegsinfekten, also Blasenentzündungen, eingesetzt wird. Der große Vorteil ist, dass es in der Regel als Einzeldosis verabreicht wird. Das heißt, eine Tablette, ein Beutel Granulat – und das war's schon! Aber warum so einfach und doch so effektiv? Fosfomycin wirkt, indem es ein Enzym blockiert, das Bakterien zum Aufbau ihrer Zellwand benötigen. Ohne eine intakte Zellwand können sich die Bakterien nicht vermehren und sterben ab. Der Clou ist, dass Fosfomycin in hoher Konzentration in der Blase ausgeschieden wird, was es zu einem idealen Kandidaten für die Behandlung von Blasenentzündungen macht. Der Nutzen liegt also in der schnellen und unkomplizierten Behandlung, die besonders für Frauen sehr angenehm ist.
Aber jetzt zur Kernfrage: Wie lange dauert es denn nun, bis man nach der Einnahme von Fosfomycin Aristo nicht mehr ständig zur Toilette rennen muss? Nun, das ist von Person zu Person etwas unterschiedlich. Im Allgemeinen berichten viele Frauen, dass sie innerhalb von 24 bis 48 Stunden eine deutliche Besserung ihrer Symptome feststellen. Das ständige Brennen beim Wasserlassen lässt nach, der Harndrang wird weniger und man kann endlich wieder entspannter durch den Tag gehen. Allerdings kann es in manchen Fällen auch etwas länger dauern, bis die volle Wirkung eintritt. Wenn nach drei Tagen keine Verbesserung eintritt, sollte man unbedingt einen Arzt aufsuchen, um andere Ursachen auszuschließen oder die Therapie anzupassen.
Auch wenn Fosfomycin Aristo ein starkes Mittel ist, ist es wichtig, den Körper bei der Heilung zu unterstützen. Genügend trinken, am besten Wasser oder ungesüßten Tee, hilft, die Bakterien auszuspülen und die Blase zu reinigen. Auch Wärme in Form einer Wärmflasche oder eines warmen Bades kann die Beschwerden lindern. Und ganz wichtig: Auf eine gute Hygiene achten, um weitere Infektionen zu vermeiden.
Wie können wir dieses Wissen nun im Alltag nutzen oder unseren Kindern spielerisch näherbringen? Man könnte beispielsweise mit Kindern ein kleines Experiment machen: Ein Glas Wasser mit Lebensmittelfarbe (für die Bakterien) füllen und dann eine "Fosfomycin"-Tablette (z.B. eine Brausetablette) hinzufügen. Beobachten, wie sich das "Bakterien"-Wasser verändert. Oder im Unterricht über die Bedeutung von Antibiotika und resistenten Bakterien diskutieren, um das Bewusstsein für den verantwortungsvollen Umgang mit Medikamenten zu schärfen. Die Möglichkeiten sind vielfältig!
Um noch tiefer in das Thema einzutauchen, könnt ihr euch online über Studien zur Wirksamkeit von Fosfomycin informieren oder in Apotheken nach Broschüren zum Thema Harnwegsinfekte fragen. Und das Wichtigste: Sprecht mit eurem Arzt oder Apotheker, wenn ihr Fragen oder Bedenken habt. Sie sind die besten Ansprechpartner, um euch individuell zu beraten und sicherzustellen, dass ihr die richtige Behandlung erhaltet. So, jetzt wisst ihr ein bisschen mehr darüber, wie Fosfomycin Aristo wirkt und wie lange es dauern kann, bis ihr wieder entspannt durch den Tag kommt!